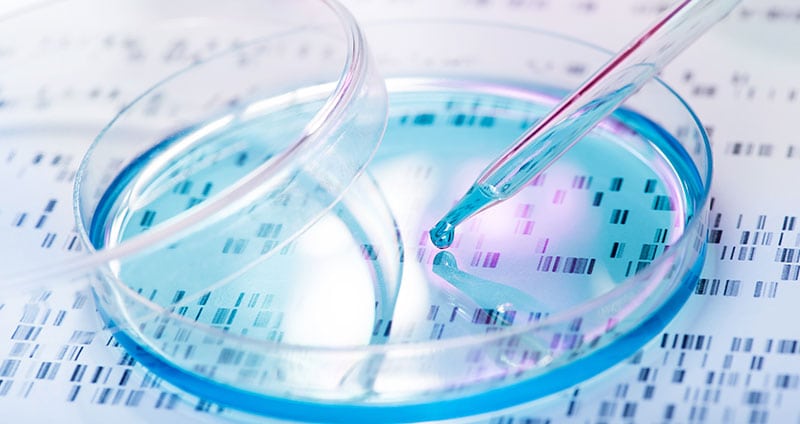

Revomex focus on the Life Science Industry is a core one. From its formative days, the company has been at the forefront of Life Sciences, Biotechnology and BioPharma research by being a supplier that is able to satisfy the researchers’ holistic needs for their project requirements. From basic essential lab equipment needed in every laboratory to state of the art new technologies, we offer equipment, core competencies in application specialization and most importantly the know-how and means of supporting such technologies and equipment from a service engineering perspective. Our commitment to delivering the best support and servicing to our customers as our primary priority has always been our strength and our one discerning trait which has placed us apart from our competition.